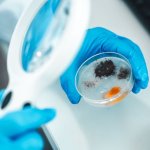

News • Diagnostics
Fast candida detection through sugar pattern analysis
Scientists created precise replicas of Candida sugar coats to understand immune responses, enabling fast bedside testing that could replace slow lab cultures.
Scientists created precise replicas of Candida sugar coats to understand immune responses, enabling fast bedside testing that could replace slow lab cultures.

Studies have found that natural polysaccharides from a medical fungus endemic to Taiwan can not only effectively inhibit inflammation, but also fight the proliferation of lung cancer cells.

The rise of pathogenic fungi is a real concern and is being driven by climate change. A new study predicts significant spread of certain fungal pathogens in Europe fuelled by rising temperatures.

A new way to inhibit the proliferation of Sars-CoV-2 opens up new perspectives in the fight against this coronavirus and other viral diseases that still have no medical treatment.

Cedars-Sinai Medical Center, a non-profit hospital and medical research institution in Los Angeles, is setting new standards for quality and innovation in patient care by successfully introducing typing of Candida auris species – a procedure that could prove crucial in protecting patients from infection outbreaks caused by these microbes in healthcare settings.

Researchers at the University of Michigan have zeroed in on Candida auris – a fungus with the uncanny ability to stick to everything from skin to catheters – and made a startling discovery.

A pioneering ‘smart contact lens’ to test the eye in a quick, non-invasive way could prevent deaths caused by fungal eye infections in developing countries.

When treating acute infections, health care providers must quickly identify the best antibiotics for fighting the infection. An automated system provides swift, accurate results for determining the best antibiotics at the right dose.

A chip-based infection model developed by Jena researchers enables live microscopic observation of damage to lung tissue caused by the invasive fungal infection aspergillosis.

A type of the antibiotic resistant superbug MRSA arose in nature long before the use of antibiotics in humans and livestock, which has traditionally been blamed for its emergence.

Recent research in Clustered Regularly Interspaced Short Palindromic Repeats (CRISPR) has identified two enzymes that can detect Covid-19 RNA as simply as a pregnancy test Jesús Pla, an eminent microbiologist at the Complutense University in Madrid, explained in our exclusive interview. CRISPR technology could help alleviate workloads in packed hospitals and expand testing to primary care and…

The COVID-19 pandemic is putting extra pressure on radiology services. Radiographers are particularly at risk of catching and spreading the disease. This is why they must follow strict cleaning and disinfection protocols, according to Pablo Valdés Solís, President of the Spanish Society of Radiology (SERAM), who has just published new guidelines on how to protect staff and patients, as the…

A common first-line treatment approach for cryptococcal meningitis in low-income countries is being compromised by the emergence of drug resistance, new University of Liverpool research warns. Published in the journal mBio, the findings highlight the need to develop new drugs and treatment regimens for the lethal brain infection, which kills around 180,000 people each year. Cryptococcal…

Researchers at the University of Arizona College of Medicine – Phoenix are cross-utilizing plant biology, medicine and engineering to create a novel platform. They have developed a revolutionary "lung on a leaf" to study pulmonary diseases.

The U.S. Food and Drug Administration is announcing a new approach to get critical updates regarding antibiotics and antifungal drugs to health care professionals as part of an overall effort to combat antimicrobial resistance. The agency created a website that will provide direct and timely access to information about when bacterial or fungal infections are likely to respond to a specific drug.…

Resident microbes living on the eye are essential for immune responses that protect the eye from infection, new research shows. The study demonstrates the existence of a resident ocular microbiome that trains the developing immune system to fend off pathogens. The research was conducted at the National Eye Institute (NEI), part of the National Institutes of Health. "This is the first…

In some cases, the Lassa virus starts with a fever and general weakness, moving toward headache, muscle pain, possible facial swelling, deafness, and worse. About 15 percent of patients hospitalized with severe cases die. Lassa fever is contagious, endemic in West Africa, and Dr. Anthony van den Pol thinks he can use it to cure ovarian cancer.

By integrating all necessary pre-analytical and analytical steps into one solution, the recently CE-marked Unyvero system, which is now commercially available in Europe, provides pathogen identification and antibiotic resistance marker information without needing expert staff and a sophisticated infrastructure, its manufacturer Curetis reports. Of even greater interest is its range of targets.

Abbott Laboratories has obtained European Union approval to market its rapid, Plex-ID instrument, along with three assays for use on the system.

The world consists of molecules – so do we. With the progression of measurement tools such as microscopes, centrifuges, or spectrometers, mankind is becoming better and better in identifying the substances from which our world is made. Today, with the technical developments in mass spectrometry, biomolecules can be weighted with the highest precision and accuracy ever known, placing it among…

TopLine, the new range of bedpan washers/disinfectors from Meiko set new standards.